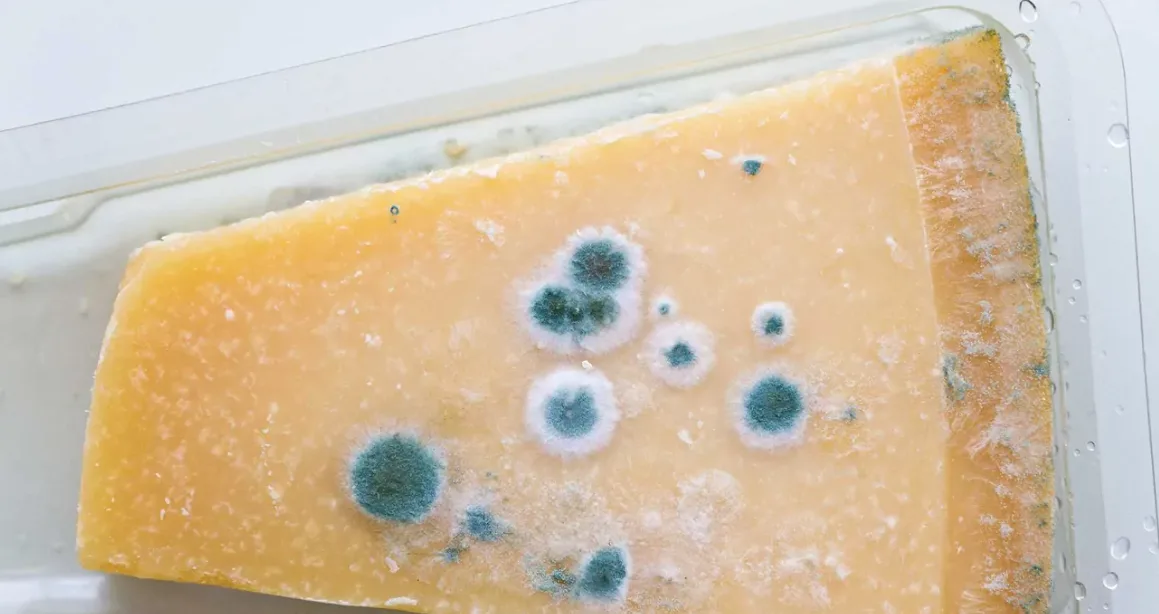

Плесень в холодильнике — неприятная и опасная проблема, с которой сталкивается каждый. Правильно установленная температура в холодильнике должна предотвратить появление плесени, но это работает не всегда. Просто положите слегка заплесневелый помидор в холодильник, и плесень начнет расти на фруктах и овощах. Иногда она возвращается на все продукты, несмотря на ваши усилия. Узнайте, как удалить плесень из холодильника и предотвратить её повторное появление.
Опасная плесень в холодильнике
Плесень в холодильнике — это токсичный грибок, который даже в малых количествах может вызвать серьезное отравление организма. Она выделяет токсины, опасные для человека. Конечно, чтобы серьезно заболеть, нужно съесть много заражённой плесенью пищи, но даже небольшое количество плесени в еде — это повод для беспокойства.
Бороться с плесенью в холодильнике сложнее, чем кажется. Белые, зеленые или цветные высолы на фруктах или в банках — явный признак обширного распространения грибка. Иногда плесень может быть невидимой, пока не достигнет этих стадий. Если в вашем холодильнике начал покрываться плесенью какой-то продукт, выбросить его может быть недостаточно — плесень быстро распространяется на другие продукты, потому что её споры сохраняются очень долго. В таком случае необходимо тщательно продезинфицировать холодильник.
Как удалить плесень из холодильника?
Если вы заметили плесень в холодильнике, а после удаления испорченных продуктов и мытья полок грибок продолжает появляться, вам нужно тщательно вымыть весь холодильник.
- Снимите все полки, дверные корзины и ящики для фруктов и овощей. Тщательно вымойте их в теплой воде с добавлением средства для мытья посуды.
- Высушите все элементы полностью перед установкой обратно в холодильник.
Следующий шаг — вымойте внутреннюю часть холодильника. Особое внимание уделите грязи под уплотнителями и в углах, которые легко пропустить. Грязные уплотнители лучше мыть пастой из воды и пищевой соды или с использованием мягкого моющего средства. Обработка уплотнителей уксусом не рекомендуется, так как они могут высохнуть и начать крошиться.
Дезинфекция холодильника от плесени
Чтобы навсегда избавиться от плесени в холодильнике, требуется дезинфекция. Для этого подойдут как химические средства, так и домашние рецепты.
- Приготовьте смесь воды и уксуса в соотношении 2:1 или используйте спирт высокой концентрации (более 60%).
- Протрите внутреннюю часть холодильника мягкой тканью, смоченной в этом растворе. Особое внимание уделите углам, щелям и сливу — именно там скапливается влага и споры плесени.
- Полки и ящики тоже стоит обработать дезинфицирующим раствором.
Если заплесневелая еда находилась в контейнере, его следует хорошо промыть и ошпарить кипятком, чтобы уничтожить споры грибка.
Причины появления плесени в холодильнике
Несмотря на низкую температуру, плесень в холодильнике может появиться по нескольким причинам:
- Частое открывание дверцы, что приводит к повышению влажности и проникновению теплого воздуха.
- Наличие испорченных, треснувших или заплесневевших продуктов, которые становятся источником спор плесени.
- Высокая влажность внутри холодильника, особенно в ящиках для фруктов и овощей.
- Плохое состояние уплотнителей дверцы, через которые проникает теплый воздух.
- Неправильный слив конденсата, засоры в сливном отверстии.
Как предотвратить появление плесени в холодильнике?
Есть несколько простых правил профилактики плесени в холодильнике:
- Следите, чтобы уплотнители дверцы были целыми и плотно прилегали, предотвращая попадание теплого воздуха.
- Ограничьте количество и длительность открывания холодильника.
- Сразу выбрасывайте слегка испорченные или треснувшие фрукты и овощи, такие как помидоры, персики, сливы и перец — они быстро становятся рассадником плесени.
- Не кладите в холодильник мокрые продукты — лишняя влага создаёт идеальные условия для роста плесени. Протирайте фрукты и овощи перед хранением.
- Регулярно вытирайте внутренние поверхности холодильника насухо, особенно ящики для овощей и фруктов.
- Используйте бумажные полотенца или специальные влагопоглощающие вкладыши в ящиках.
- Проверяйте и чистите сливное отверстие от грязи и засоров.